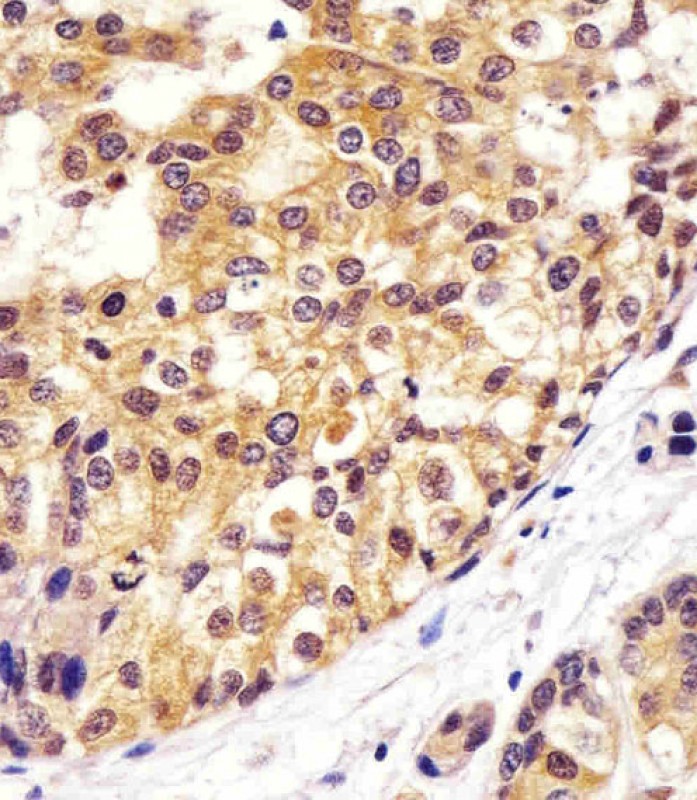

> Antigen, Antibodies, ELISA, Western Blot > Primary Antibody > Monoclonal Antibodies > VCP AntibodyBrand |
Leading Biology | Catalog Number |
APR10677G |
Product Type |
Monoclonal Antibodies | Field of Research |
|
Product Overview |
We constantly strive to ensure we provide our customers with the best antibodies. As a result of this work we offer this antibody in purified format.
We are in the process of updating our datasheets. If you have any questions regarding this update, please feel free to contact our technical support team.
This product is a high quality VCP antibody.
|
||
Molecular Weight |
89322 Da
|
||
Cellular Localization |
Antigen Cellular Localization:
Cytoplasm, cytosol. Endoplasmic reticulum. Nucleus. Note=Present in the neuronal hyaline inclusion bodies specifically found in motor neurons from amyotrophic lateral sclerosis patients. Present in the Lewy bodies specifically found in neurons from Parkinson disease patients. Recruited to the cytoplasmic surface of the endoplasmic reticulum via interaction with AMFR/gp78. Following DNA double-strand breaks, recruited to the sites of damage. Recruited to stalled replication forks via interaction with SPRTN
|
||
Host |
Mouse
|
||
Species Reactivity |
Human, Mouse, Rat
|
||
Target |
This VCP antibody is generated from a mouse immunized with a recombinant protein of human TERA.
|
||
Clone |
1563CT163.48.77
|
||
Isotype |
IgG1,κ
|
||
GeneID |
|||
UniProt ID |
|||
Function |
Necessary for the fragmentation of Golgi stacks during mitosis and for their reassembly after mitosis. Involved in the formation of the transitional endoplasmic reticulum (tER). The transfer of membranes from the endoplasmic reticulum to the Golgi apparatus occurs via 50-70 nm transition vesicles which derive from part-rough, part-smooth transitional elements of the endoplasmic reticulum (tER). Vesicle budding from the tER is an ATP-dependent process. The ternary complex containing UFD1L, VCP and NPLOC4 binds ubiquitinated proteins and is necessary for the export of misfolded proteins from the ER to the cytoplasm, where they are degraded by the proteasome. The NPLOC4-UFD1L-VCP complex regulates spindle disassembly at the end of mitosis and is necessary for the formation of a closed nuclear envelope. Regulates E3 ubiquitin-protein ligase activity of RNF19A. Component of the VCP/p97-AMFR/gp78 complex that participates in the final step of the sterol-mediated ubiquitination and endoplasmic reticulum-associated degradation (ERAD) of HMGCR. Also involved in DNA damage response: recruited to double-strand breaks (DSBs) sites in a RNF8- and RNF168-dependent manner and promotes the recruitment of TP53BP1 at DNA damage sites. Recruited to stalled replication forks by SPRTN: may act by mediating extraction of DNA polymerase eta (POLH) to prevent excessive translesion DNA synthesis and limit the incidence of mutations induced by DNA damage. Required for cytoplasmic retrotranslocation of stressed/damaged mitochondrial outer-membrane proteins and their subsequent proteasomal degradation.
|
||
Summary |
Necessary for the fragmentation of Golgi stacks during mitosis and for their reassembly after mitosis. Involved in the formation of the transitional endoplasmic reticulum (tER). The transfer of membranes from the endoplasmic reticulum to the Golgi apparatus occurs via 50-70 nm transition vesicles which derive from part-rough, part-smooth transitional elements of the endoplasmic reticulum (tER). Vesicle budding from the tER is an ATP-dependent process. The ternary complex containing UFD1L, VCP and NPLOC4 binds ubiquitinated proteins and is necessary for the export of misfolded proteins from the ER to the cytoplasm, where they are degraded by the proteasome. The NPLOC4-UFD1L-VCP complex regulates spindle disassembly at the end of mitosis and is necessary for the formation of a closed nuclear envelope. Regulates E3 ubiquitin-protein ligase activity of RNF19A. Component of the VCP/p97-AMFR/gp78 complex that participates in the final step of the sterol-mediated ubiquitination and endoplasmic reticulum-associated degradation (ERAD) of HMGCR. Also involved in DNA damage response: recruited to double-strand breaks (DSBs) sites in a RNF8- and RNF168-dependent manner and promotes the recruitment of TP53BP1 at DNA damage sites. Recruited to stalled replication forks by SPRTN: may act by mediating extraction of DNA polymerase eta (POLH) to prevent excessive translesion DNA synthesis and limit the incidence of mutations induced by DNA damage. Required for cytoplasmic retrotranslocation of stressed/damaged mitochondrial outer-membrane proteins and their subsequent proteasomal degradation.
|
||
Form |
Purified monoclonal antibody supplied in PBS with 0.09% (W/V) sodium azide. This antibody is purified through a protein G column, followed by dialysis against PBS. |
||
Storage & Stability |
Store at +4°C short term. For long-term storage, aliquot and store at -20°C or below. Stable for 12 months at -20°C. Avoid repeated freeze-thaw cycles.
|
||
Applications |
WB, IHC-P, IF, FC, E
|
||
Dilution |
IF~~1:25
IHC-P~~1:25
WB~~1:4000
FC~~1:25
|
||
Synonyms |
Transitional endoplasmic reticulum ATPase, TER ATPase, 15S Mg(2+)-ATPase p97 subunit, Valosin-containing protein, VCP, VCP
|
||
Images |

Immunofluorescent analysis of 4% paraformaldehyde-fixed, 0. 1% Triton X-100 permeabilized HeLa (human cervical epithelial adenocarcinoma cell line) cells labeling VCP with APR10677G at 1/25 dilution, followed by Dylight? 488-conjugated goat anti-mouse IgG (NA166821) secondary antibody at 1/200 dilution (green). Immunofluorescence image showing cytoplasm and nucleus staining on HeLa cell line. Cytoplasmic actin is detected with Dylight? 554 Phalloidin (PD18466410) at 1/100 dilution (red).
APR10677G staining VCP in human breast carcinoma sections by Immunohistochemistry (IHC-P - paraformaldehyde-fixed, paraffin-embedded sections). Tissue was fixed with formaldehyde and blocked with 3% BSA for 0. 5 hour at room temperature; antigen retrieval was by heat mediation with a citrate buffer (pH6). Samples were incubated with primary antibody (1/25) for 1 hours at 37°C. A undiluted biotinylated goat polyvalent antibody was used as the secondary antibody. 
All lanes : Anti-VCP Antibody at 1:4000 dilution Lane 1: Hela whole cell lysate Lane 2: K562 whole cell lysate Lane 3: A549 whole cell lysate Lane 4: C6 whole cell lysate Lane 5: U-87 MG whole cell lysate Lane 6: NIH/3T3 whole cell lysate Lysates/proteins at 20 μg per lane. Secondary Goat Anti-mouse IgG, (H+L), Peroxidase conjugated at 1/10000 dilution. Predicted band size : 89 kDa Blocking/Dilution buffer: 5% NFDM/TBST. |
||
Specification |
|||
Quantity |
|
||
| Select | Brand | Catalog No. | Product Name | Pack Size | Type | Field of Research | Specification | Quantity | Price(USD) | |
| 1 | Leading Biology | APG02467G | CCK4 / PTK7 Antibody (clone 4F9) | 50 μl | Monoclonal Antibodies |
|
$495.00 | Add Ask | ||
| 2 | Leading Biology | AMM04683G | GALT Antibody (clone 4C11) | 50 μg | Monoclonal Antibodies |
|
$545.00 | Add Ask | ||
| 3 | Leading Biology | AMM01402G | Vimentin (Mesenchymal Cell Marker) Antibody - With BSA and Azide | 50 ug | Monoclonal Antibodies |
|
$395.00 | Add Ask | ||
| 4 | Leading Biology | APR08280G | LTA4H / LTA4 Antibody (clone 9G8) | 50 μl | Monoclonal Antibodies |
|
$495.00 | Add Ask | ||
| 5 | Leading Biology | AMM00172G | CD1a / HTA1 (Mature Langerhans Cells Marker) Antibody - With BSA and Azide | 50 ug | Monoclonal Antibodies |
|
$395.00 | Add Ask | ||
| 6 | Leading Biology | AMM05750G | CEBPA Antibody | 100 μl | Monoclonal Antibodies |
|
$545.00 | Add Ask |
 Leading Biology Inc.
2600 Hilltop DR, Building G, B Suite C138
Richmond, CA, 94806
Tel: 1-661-524(LBI)-0262
Email: info@leadingbiology.com
Leading Biology Inc.
2600 Hilltop DR, Building G, B Suite C138
Richmond, CA, 94806
Tel: 1-661-524(LBI)-0262
Email: info@leadingbiology.com
Complete this form and click send to ask us a question, request a quote or simply say hello.

You have 0 item in your cart

You have 0 item in your inquiry list
